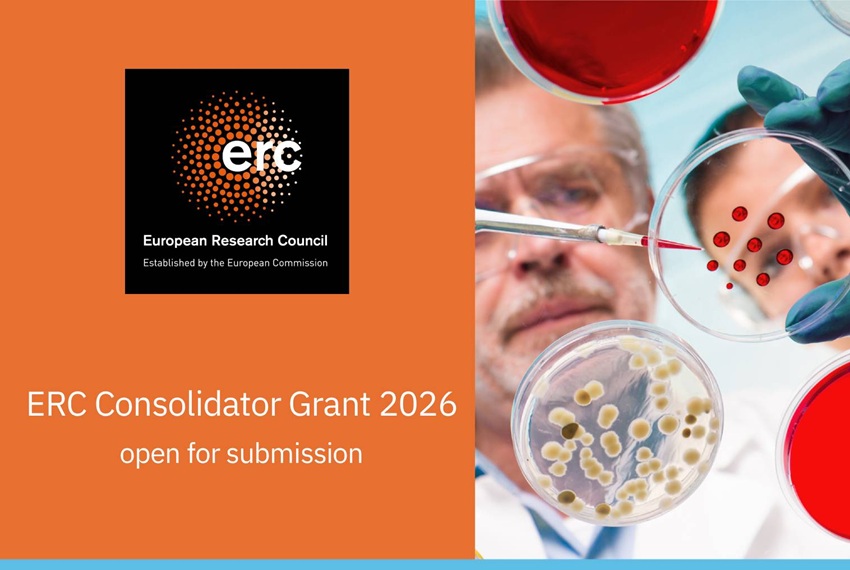

Europejska Rada ds. Badań Naukowych (ERC) otworzyła nabór wniosków w ramach konkursu ERC Consolidator Grant 2026. Wnioski można składać do 13 stycznia 2026 r. do godz. 17:00 (Brussels time).
ERC Consolidator Grant jest przeznaczony dla naukowców 7–12 lat po doktoracie. O grant mogą starać się osoby, które obroniły doktorat między 1 stycznia 2014 r. a 31 grudnia 2018 r. (włącznie). Projekt może być realizowany w dowolnej instytucji zlokalizowanej w państwie członkowskim UE lub kraju stowarzyszonym z programem Horyzont Europa.
Wnioskodawcy mogą ubiegać się o maksymalnie 2 mln euro na 5 lat, a ponadto do 1 mln euro na pokrycie kosztów kwalifikowalnych wykraczających poza podstawowy budżet. Badacze aktualnie pracujący poza Europą, którzy przeniosą się, aby realizować grant ERC w instytucji z UE lub kraju stowarzyszonego z Horyzontem Europa, mogą wnioskować o wsparcie relokacyjne do 2 mln euro.
ERC wspiera realizację ambitnych badań we wszystkich dziedzinach nauki, prowadzących do przełomowych wyników. Temat projektu określa wnioskodawca, a jedynym kryterium oceny jest doskonałość naukowa.
Dokumenty konkursowe (w tym Przewodnik dla wnioskodawców) są dostępne na stronie konkursu. Wnioski składa się elektronicznie poprzez Funding & Tenders Portal.
Zachęcamy również do skorzystania z koordynowanej przez Krajowy Punkt Kontaktowy w NCBR ERC Mentoring Initiative!